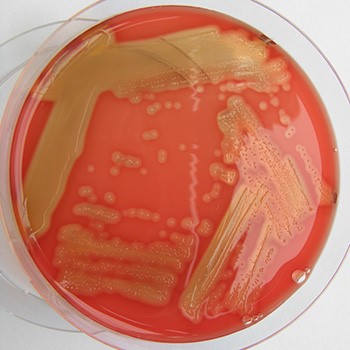

“马腺疫”,又称“槽结”,是由于马腺疫链球菌马亚种(Streptococcus equi ssp. zooepidemicus, SEZ)所引起马属动物的一种急性接触性传染病,属于三类动物疫病。当饲养管理不良、气候骤变感冒、长途运输、过度使役导致马体抵抗力降低时,呈致病作用发生腺疫。该病在6个月至5岁的青年马匹中具有很高的发病率,另外,在育种场和比赛训练场地常常会周期性爆发。
病原体随病马的脓汁和鼻液喷鼻排出并污染、场地、马衣、饲草及人(手、衣服、胃管等),经呼吸道和消化道感染,在健康马的上呼吸道粘膜和扁桃体有时也存在毒力较弱的马腺疫链球菌。
本病潜伏期为3-10天,根据年龄、免疫情况、畜群管理情况不同发病率有所变化。在国内管理不良马场发病率接近100%。管理良好的发病畜群死亡率通常小于5%,并通常与继发性肺炎和上呼吸道阻塞相关。
引进处于潜伏或恢复期的马匹通常是使未患病的马群受到感染的细菌来源。本病无明显前因突然爆发的原因尚未清楚,但近年来调查显示存在慢性带菌者,这些带菌者很可能是本病爆发的具体原因。
症状
体温升高(40—41℃),初始症状为颌下淋巴结热痛肿大并伴有食欲不振,严重时填满整个下颌间隙。中后期破溃,流出黄白色粘稠脓汁,体温下降。鼻粘膜潮红,流出大量浆液性混浊鼻汁,渐成粘性及脓性。咳嗽并伴有有呼吸和吞咽困难。
脓肿发生位置可能会有所改变,包括眶周、咽喉淋巴结、喉囊、肺/胸腔、腹腔(肝、脾、肾,及肠系膜),偶发脑和关节。发生转移性病灶的病例称为“恶性马腺疫”,通常伴有慢性体重减轻。
临床症状可能持续几天到几个月,对于大多数病例,一旦淋巴结脓肿破溃,病马往往能够很快痊愈。




诊断
诊断最好是将临床症状(精神沉郁,体温升高,淋巴肿大)和链球菌的分离结合起来进行。用棉签从鼻部采样脓性分泌物,或直接从未破溃脓肿处吸出物质(理想情况采样)进行细菌分离培养。
治疗
青霉素钠,15000-20000IU/kg,静脉注射,每6hr用药一次,症状消失后给药还应持续6-7d,否则可能导致该病复发。其他可考虑使用的药物有半合成青霉素、头孢噻呋、甲氧苄啶-磺胺制剂和土霉素等链球菌敏感药物,但价格较贵且效果一般。
使用非甾体抗炎药,如保泰松,初24hr给药4.4mg/kg以后每12hr给药2.2mg,肌注,控制体温和炎性反应,并能一定程度上提高食欲。也可用氟尼辛葡甲胺。
颌下淋巴结硬肿时,宜热敷,然后涂擦碘酊。当肿胀出现波动时,消毒波动处切开排脓,使用0.1%高锰酸钾溶液冲洗。
大多数轻症病例可能不需要抗生素治疗就能自行恢复。恶性病症常常需要延长抗生素治疗时间(4-6周)和局部治疗(引流排脓),以及抗炎治疗。
预防
1、严防病马混入健康马群。新引进的幼驹应隔离观察2周。
2、加强对幼驹的饲养管理,防止感冒,增强体质。
3、在春、秋气候骤变易发病季节,应勤检疫,发现病畜立即隔离治疗。病畜厩舍和污染的用具等,应用3%的来苏儿等消毒。
管理
采取适当的隔离措施将显著提高预防马腺疫的机会。对于新引进的马匹,应该适当隔离2-3周并定
病马须隔离治疗,曾经处理过患马的人员不得与未感染马匹接触,每次处理后仔细清洗手部和防护靴,并穿着一次性防护服,对于食物、护理用品及反复使用的收益器械必须进行消毒处理。


